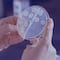
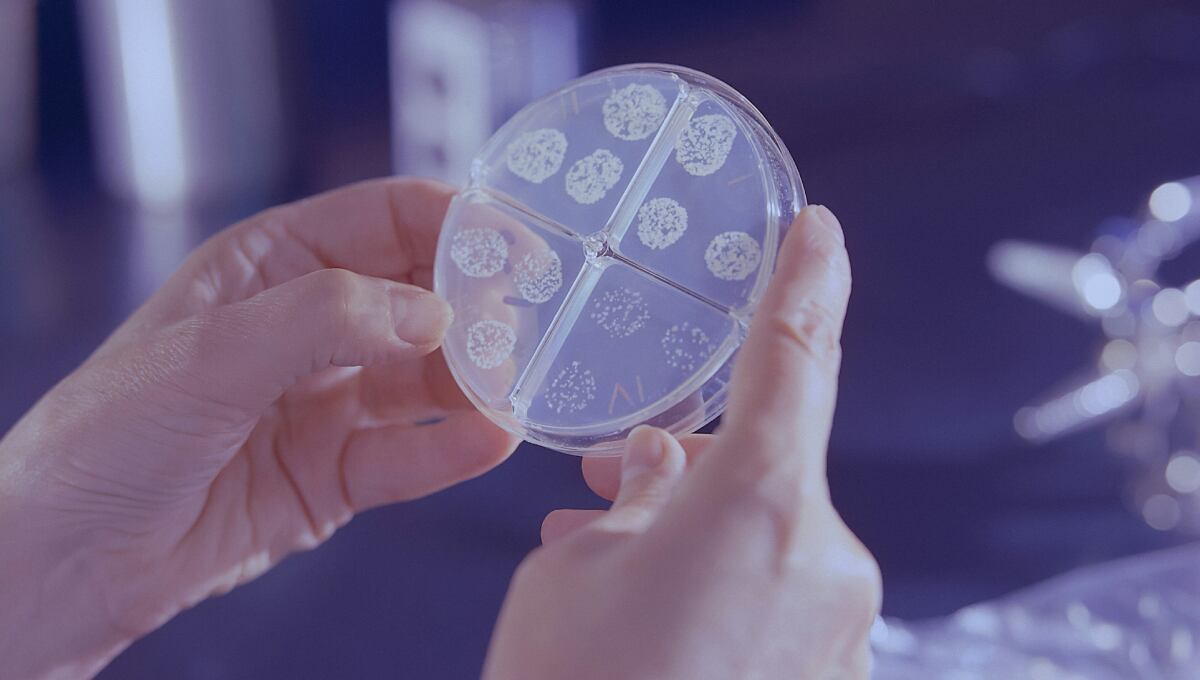
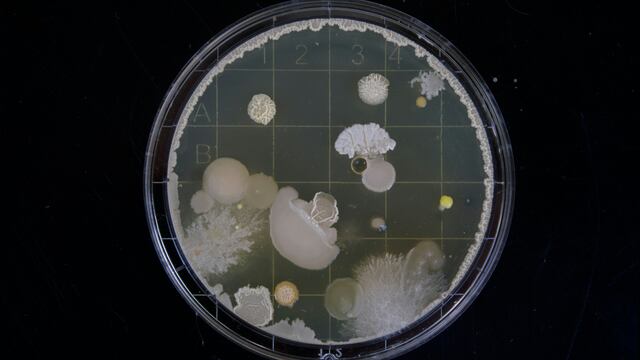
Bacteria

Japón ha emitido una alerta por el aumento de casos síndrome de shock tóxico estreptocócico, los cuales llegaron a 977 en lo que va de 2024 y son provocados por una bacteria carnívora.
Esta cifra supera los 941 casos de infección por esta bacteria carnívora que se dieron en Japón durante todo 2023.
Si bien el gobierno japonés ha rastreado la enfermedad desde 1999, los últimos reportes informan que los contagios han aumentado de manera exponencial desde hace dos años.

Al punto que para finales de este año se podrían llegar a los 2 mil 500 casos reportados, con una tasa de muerte del 30%.
¿Cómo actúa la bacteria carnívora de Japón?
De acuerdo con los reportes sobre la bacteria carnívora de Japón, es un estreptococo del grupo A (GAS) que por lo general ataca a los niños, produciendo dolor e hinchazón en la garganta.
Dicha bacteria carnívora tiene los mismos síntomas en adultos, con la diferencia que el dolor e hinchazón pasa a las extremidades, además de provocar fiebre y presión baja.
A esto le sigue la necrosis, problemas respiratorios, insuficiencia orgánica y muerte. Ken Kikuchi, profesor de la Universidad Médica Femenina de Tokio, señala que todo ocurre en 48 horas.
Una persona puede notar hinchazón en un pie en la mañana, lo cual se va expandiendo con el pasar de las horas, hasta la muerte dos días después.
De momento, la única forma de prevenir esto es que se tenga una buena higiene de manos, además de tratar rápidamente cualquier herida abierta, por mínima que sea.

La bacteria carnívora de Japón ya es un problema mundial
Si bien Japón es quien ha dado más de qué hablar con la bacteria carnívora, la realidad es que se trata de un padecimiento extranjero que habría llegado al país.
Desde 2022, la OMS advirtió que por lo menos 5 países de Europa sufren del casos de shock tóxico estreptocócico desde 2022, los cuales también van en aumento.
Se cree que visitantes (ya sea turistas o trabajadores) europeos que han entrado a Japón en los últimos años, habrían introducido la mencionada bacteria carnívora.
La misma OMS ha mencionado que todo esto comenzó desde que los países del mundo relajaron sus medidas sanitarias tras el Covid-19.